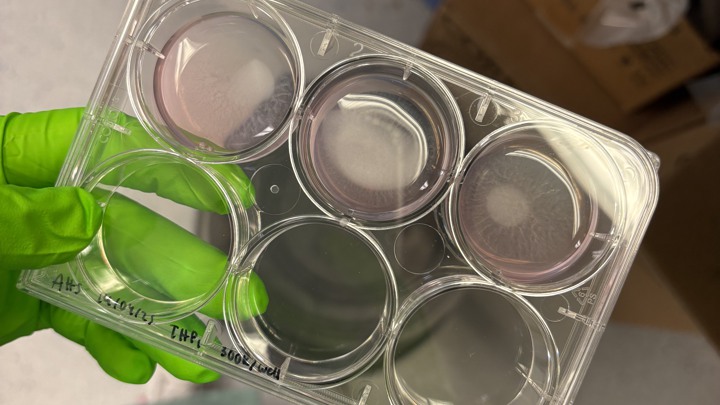
A gloved hand holding a six-pot tray in the lab.

Choose Medicine
A wide range of courses
Whether you want to gain specialist knowledge in a specific area, brush up on your skills as a scientist or go into research, we have a taught master's course in medicine for you.
Manchester is home to both one of the largest medical schools in the UK and top researchers working at the forefront of the medical field.
We offer postgraduate taught courses covering a wide range of disciplines for students from both medical and non-medical backgrounds.
Why choose Manchester?
Become a specialist
Specialist courses cover occupational, aesthetic and musculoskeletal medicine, paediatric anaesthesia, and medical education.
You’ll learn from educators based in local hospitals and specialist NHS services. Some courses, such as our MSc in Medical and Molecular Virology, cover relevant topics such as COVID-19.

Start your research training
We offer master's courses that are designed to help you prepare for PhD study and a career in medical research, giving you a head start if you want to become a research scientist.

From our students
How my MSc in Medical Virology shaped Rwanda’s blood safety efforts
Biomedical scientist Henri discusses his Manchester MSc and how it has prepared him for his current role.
Read the blog : How my MSc in Medical Virology shaped Rwanda’s blood safety efforts

My journey studying genomic medicine at Manchester
Nishi reflects on her time on the Genomic Medicine MSc at Manchester.
Read the blog : My journey studying genomic medicine at Manchester

What three months in the lab have really taught me
MSc Tissue Engineering for Regenerative Medicine student Andrea walks us through her research project.
Read the blog : What three months in the lab have really taught me
How my master's will aid research into HIV in Malawi
Michael explains how the MSc Medical and Molecular Virology course will help him to better understand HIV in his home country.
Read the blog : How my master's will aid research into HIV in Malawi

Arriving at Manchester as an international master's student
MSc Medical and Molecular Virology student Rohith talks about settling in to life in Manchester as an Indian student.
Read the blog : Arriving at Manchester as an international master's student

Studying clinical immunology as an international student
Ethiopian researcher and clinician Abel looks back on his Manchester MSc in Clinical Immunology.
Read the blog : Studying clinical immunology as an international student

Starting my MSc as an international student
Mexican student Andrea talks about her first experiences on the MSc Tissue Engineering for Regenerative Medicine course.

Technology platforms
Access unique facilities
Depending on your area of interest, you'll have access to world-leading facilities such as our Genome Editing Unit, which is the only UK core facility that both uses CRISPR-Cas9 and trains others to do so.
Students on our clinical courses will benefit from Manchester's close links to local NHS hospitals, with the opportunity to explore real-life clinical scenarios as part of your studies.
CRISPR – the future of genetic research at Manchester?
CRISPR is quite literally changing the world around you – and Manchester is leading the way.
Read the story CRISPR: The future of genetic research at Manchester?

Courses
Master's courses
Healthcare science courses
- Clinical Biochemistry (MSc)
- Clinical Immunology (MSc)
- Medical and Molecular Virology (MSc)
- Medical Microbiology (MSc)
- Medical Physics in Cancer Radiation Therapy (MSc)
- Molecular Pathology of Cancer (MSc)
Specialist courses
- Neuroimaging for Clinical & Cognitive Neuroscience (MSc)
- Occupational Hygiene (MSc)
- Occupational Medicine (MSc)
- Physician Associate Studies (MSc)
- Skin Ageing and Aesthetic Medicine (MSc - blended learning)
- Master of Public Health (MPH) [online]
- Master of Public Health (MPH) [on campus]
- Transformative Oncology (MSc/PGDip/PGCert)
Medical research courses
- Cancer Research and Molecular Biomedicine (MSc)
- Cardiovascular Health and Disease (Research) (MSc)
- Development Biology and Stem Cells (Research) (MSc)
- Genomic Medicine (MSc)
- Oncology Research (MSc)
- Precision Medicine (MSc)
- Public Health (MRes)
- Reproduction and Pregnancy (Research) (MSc)
- Tissue Engineering for Regenerative Medicine (MSc)
Data and communication courses
- Applied AI for Medical Imaging (MSc)
- Health Data Science (MSc)
- Health Informatics (MSc) [jointly awarded by UCL and Manchester]
- History of Science, Technology and Medicine (MA)
- Medical and Health Education (PGCert)
- Science and Health Communication (MSc)
PhD with integrated master's
If you're planning to undertake a PhD after your master's, our Integrated PhD programme will enable you to combine your postgraduate taught course with a related PhD project in biology, medicine or health.

Making an application
Apply for Medicine
If you have any questions, email us at pgtaught.medicine@manchester.ac.uk.
If you’re ready to apply to a postgraduate medicine degree at Manchester, here’s what you need to know.
